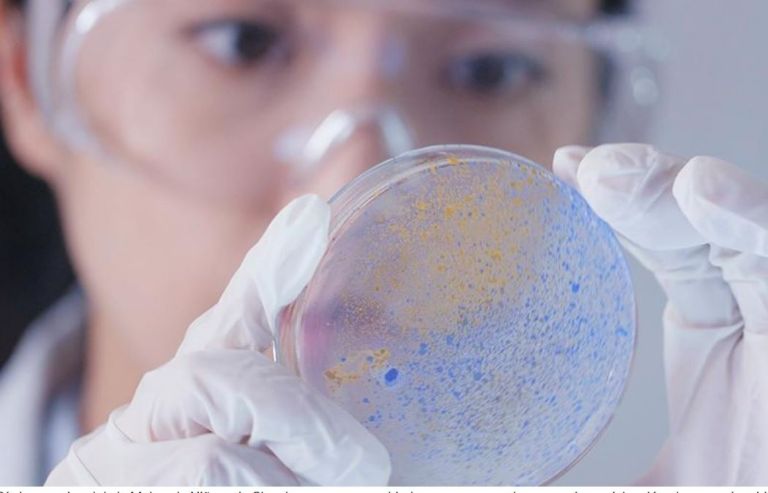
Día Internacional de la Mujer y la Niña en la Ciencia

Ciudad de México.- Este domingo 11 de febrero se conmemora el Día Internacional de la Mujer y las Niña en la Ciencia, cuyo objetivo es acabar con la brecha de género en diferentes ámbitos del aprendizaje; sin embargo, muchas personas se preguntan sobre las razones que llevaron a las autoridades a declarar esta fecha en el segundo mes del año y las consecuencias de su implementación a nivel mundial.
La igualdad de género ha sido siempre un tema central de la Organización de las Naciones Unidas (ONU), la Asamblea general asegura que la igualdad entre los géneros y el empoderamiento de las mujeres y las niñas contribuirán decisivamente no solo al desarrollo económico del mundo, sino también al progreso respecto de todos los objetivos y metas de la Agenda 2030 para el Desarrollo Sostenible, por lo que destacó la importancia de sus actividades en la ciencia
La Asamblea General declaró el 11 de febrero Día Internacional de las Mujeres y las Niñas en la Ciencia en reconocimiento al papel clave que desempeñan las mujeres en la comunidad científica y la tecnología, tiene como objetivo promover a las mujeres y las niñas en la ciencia. Este Día es una oportunidad para promover el acceso y la participación plenos y equitativos en la ciencia para mujeres y niñas.
La igualdad entre hombres y mujeres es una prioridad y el apoyo a las jóvenes, su educación y su plena capacidad para hacer oír sus ideas son los motores del desarrollo y la paz. Este año, la UNESCO organiza un evento sobre el tema "Cerrar la brecha de género en la ciencia: acelerar la acción" el 9 de febrero de 2024. Es importante recordar que ha habido brechas de género significativas en todos los niveles de ciencia, tecnología, ingeniería y matemáticas en todo el mundo.
Si bien las mujeres han logrado grandes avances en el aumento de su participación en la educación superior, siguen estando poco representadas en estos campos. México ha dado al mundo grandes científicas, entre las que destaca la Dra. Esperanza Martínez Romero, investigadora del Centro de Ciencias Genómicas de la UNAM, Dra. Sandra Pascoe Ortiz, profesora investigadora en la Universidad del Valle de Atemajac (UNIVA) en Guadalajara, Jalisco, cuyos inventos favorecieron al desarrollo de la humidad.
Fuente: Tribuna, ONU









